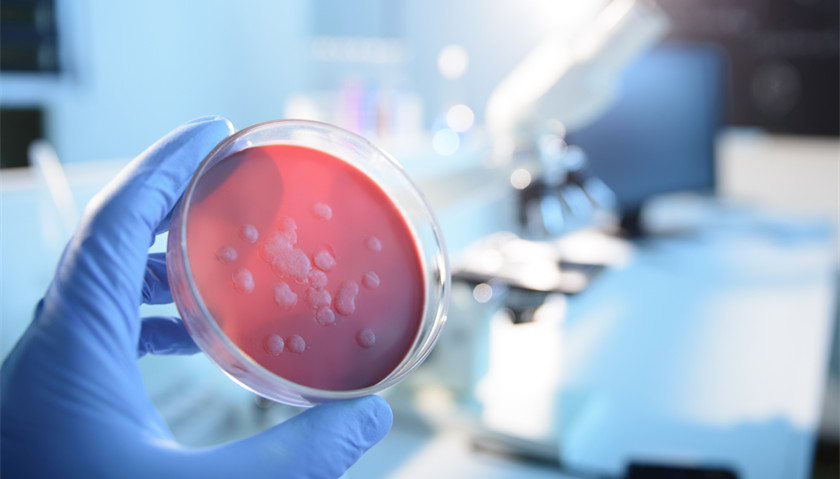

今天,国家卫生健康委公布了《中华人民共和国传染病防治法》(修订草案征求意见稿),其中,在甲乙丙三类法定传染病的基础上增加“具备传染病流行特征的不明原因聚集性疾病”,并进一步完善报告、管控方面的针对性措施;同时将建设方舱医院等成功做法上升为法律规定。
《中华人民共和国传染病防治法》(修订草案征求意见稿)总结了重大疫情各项防控工作的成功经验,将其上升为法律制度。同时,坚持问题导向,总结分析此次疫情防控中暴露出的短板和弱项,找准重点难点问题,有针对性地开展修法工作,完善制度不足、增强法律的有效性、可操作性。
重点突出不明原因聚集性疾病防控
征求意见稿在修订内容中,强调“坚持政府主导、依法防控、科学防控、联防联控、群防群控”的防控原则;构建和完善传染病防控的领导体制机制,建立联防联控机制,进一步强化四方责任。同时,完善传染病分类制度,明确甲乙丙三类传染病的特征,对不同类别传染病在监测范围、报告主体、报告时限等方面进行了区别规定,进一步突出重点,体现分类管理的理念。
征求意见稿还重点突出了不明原因聚集性疾病防控。在甲乙丙三类法定传染病的基础上增加“具备传染病流行特征的不明原因聚集性疾病”,并进一步完善报告、管控方面的针对性措施。具体来说,对乙类传染病中传染性非典型肺炎、炭疽中的肺炭疽和新型冠状病毒肺炎,采取本法所称甲类传染病的预防、控制措施。其他乙类传染病和具备传染病流行特征的不明原因聚集性疾病需要采取本法所称甲类传染病的预防、控制措施的,由国务院卫生健康主管部门及时报经国务院批准后予以公布、实施。
同时要求疾病预防控制机构应当设立或者指定专门的部门、人员负责传染病疫情信息管理工作,主动收集、分析、调查、核实传染病疫情信息。疾病预防控制机构接到甲类传染病疫情报告或者具备传染病流行特征的不明原因聚集性疾病以及其他传染病暴发、流行时,应当在2小时内完成疫情信息核实及向当地卫生健康主管部门的报告,由当地卫生健康主管部门立即报告当地人民政府,同时报告上级卫生健康主管部门和国务院卫生健康主管部门。
国家对发现并报告具备传染病流行特征的不明原因聚集性疾病、新发传染病疫情的单位和个人按照国家有关规定予以奖励;对经确认排除传染病疫情的,不予追究相关单位和个人责任。
此外,对于新发传染病、具备传染病流行特征的不明原因聚集性疾病,在病原体、传染力、致病力等情况尚不明确时,县级以上人民政府经评估认为确有必要的,可预先采取甲类传染病预防、控制措施,同时立即上报上级人民政府。
建设方舱医院等做法上升为法律规定
征求意见稿还完善了传染病疫情监测、预警和报告制度。例如,多渠道开展监测,建立临床医疗、疾病控制信息的互通共享制度,建立跨部门、跨地域的监测信息共享机制; 明确了各级各类机构的报告责任及时限要求,建立报告奖励和责任豁免制度。
同时,强调了重构传染病疫情信息公布制度。由中国疾控中心定期公布全国法定传染病疫情信息,县级以上疾控机构定期公布本行政区域法定传染病疫情信息。传染病暴发、流行时,由县级以上地方人民政府卫生健康主管部门公布本行政区域内疫情信息;传染病出现跨省暴发、流行时,由国务院卫生健康主管部门负责公布。
在完善防控措施方面,要求建立由传染病专科医院、综合性医院、中医医院、院前急救机构、临时性救治场所等构成的综合救治体系,根据患者疾病分型和病情进展情况进行分级、分层、分流的救治;增加公安、工信、交通等部门配合疾控部门开展流调职责,强化大数据等技术手段作用,增加分区分级精准防控相关规定。
此外,将健全传染病救治网络建设。构建平战结合的综合救治体系,将建设方舱医院等成功做法上升为法律规定,发挥中医药在传染病治疗中的作用。例如,县级以上人民政府应当完善体育场馆、会展场馆、市民活动中心以及学校等公共基础设施的建设和改造,为重大疫情发生时的应急医疗救治和患者隔离需求预留接口,便于紧急需要时作为临时性救治场所或隔离区域迅速投入使用。
现场处理疫情等人员将给予津贴
征求意见稿加强传染病防控制度保障,在明确传染病救治相关费用支付承担规则,建立应急物资、能力储备制度。
其中规定,国家将传染病防治必需的药品、医疗器械、诊疗项目纳入医保支付范围并实行动态调整。对患有特定传染病的困难人群实行医疗救助,减免医疗费用。对于甲类传染病患者和疑似患者在基本医保、大病保险、医疗救助等按规定支付后,个人负担部分由中央和地方财政给予全额补助。
此外,鼓励商业保险公司针对新发传染病开发保险产品,将意外险、疾病险等产品的保险责任范围扩展至新发传染病等重大疾病。
对从事传染病预防、医疗、科研、教学、监督执法及现场处理疫情的人员,以及在生产、工作中接触传染病病原体的其他人员采取有效的卫生防护措施和医疗保健措施,给予适当津贴,并建立动态调整机制。
对直接参与国内传染病类突发公共卫生事件现场调查处置、患者救治、国境卫生检疫、动物防疫等各类一线工作的人员,以及政府选派直接参与国外重大传染病疫情防治工作的医疗和公共卫生等防控人员,根据工作风险、强度和时间给予临时性工作补助。
不配合实施传染病防控措施可拘留并罚款
征求意见稿加大了相关违法行为的处罚力度,并增加对个人和单位不配合实施传染病防控措施等情形的处罚规定。
传染病暴发、流行时,单位和个人有下列行为之一的,由公安机关予以警告或处二千元以下罚款;情节严重的,处五日以上十日以下拘留,可以并处五千元以下罚款:拒不履行政府发布的防控决定、命令的;拒不接受或配合疾病预防控制机构采取的流行病学调查等防控措施的;故意隐瞒传染病病情的;患者、病原携带者、疑似患者、密切接触者拒绝接受隔离治疗或医学观察的,以及擅自脱离隔离治疗和医学观察的;编造、故意传播虚假疫情信息的;有其他干扰、阻碍、妨害传染病疫情防控行为的。
县级以上人民政府卫生健康主管部门将联合有关部门建立传染病防控违法机构和人员信用记录制度,纳入全国信用信息共享平台,依法实施联合惩戒。
来源:北京日报客户端



评论